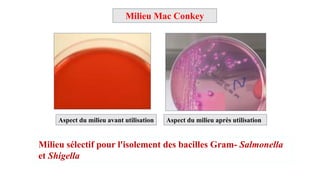
Milieu Mac Conkey
Milieu sélectif pour l'isolement des bacilles Gram- Salmonella
et Shigella
Aspect du milieu avant utilisation Aspect du milieu après utilisation

Le document traite de la microbiologie alimentaire, en détaillant la physiologie des microorganismes, les contaminations, ainsi que les normes microbiologiques applicables aux produits alimentaires. Il aborde également les exigences des microorganismes en matière de culture, les types de milieux de culture, et les méthodes de conservation des bactéries. Enfin, il décrit les critères microbiologiques et les conditions nécessaires pour garantir la sécurité sanitaire des aliments.